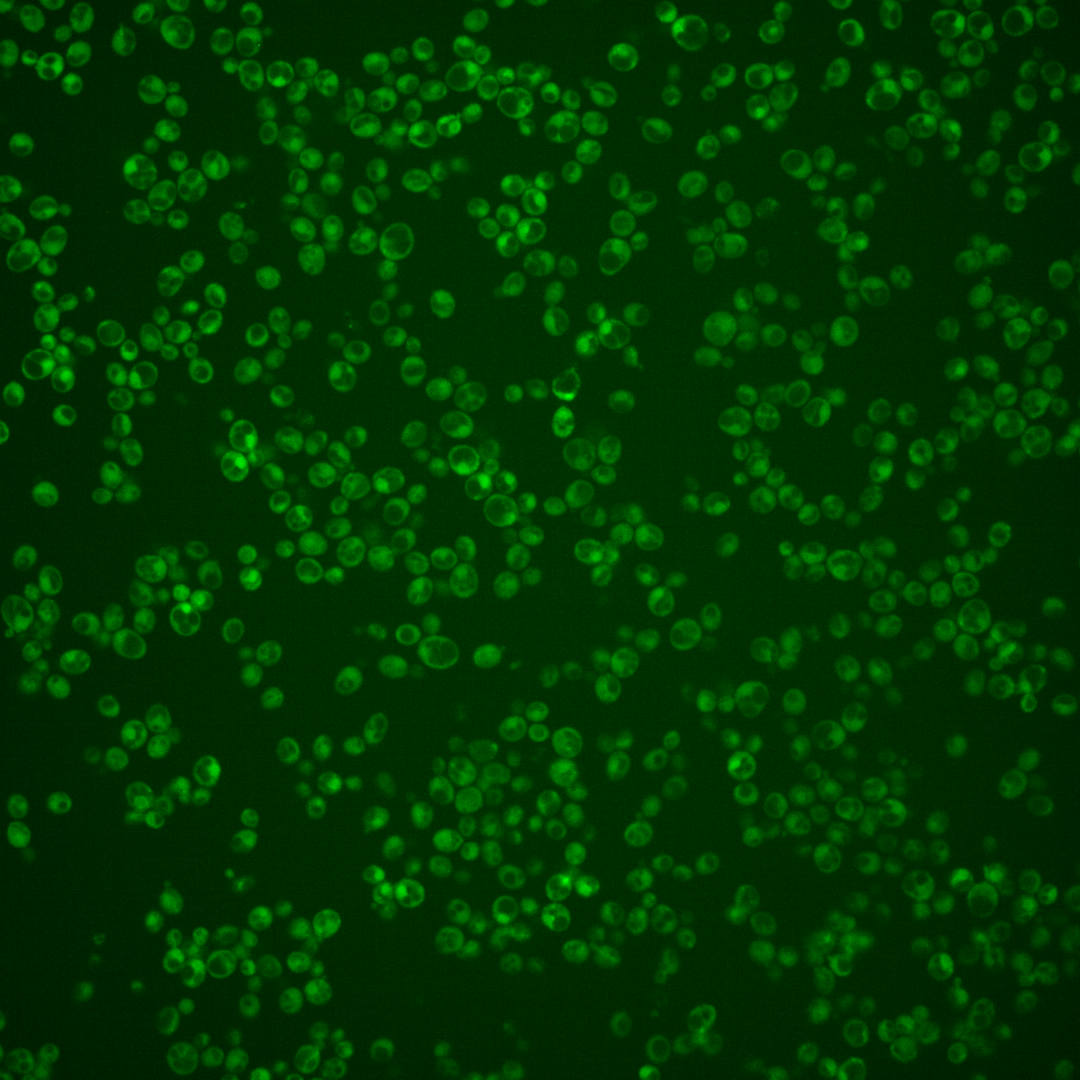
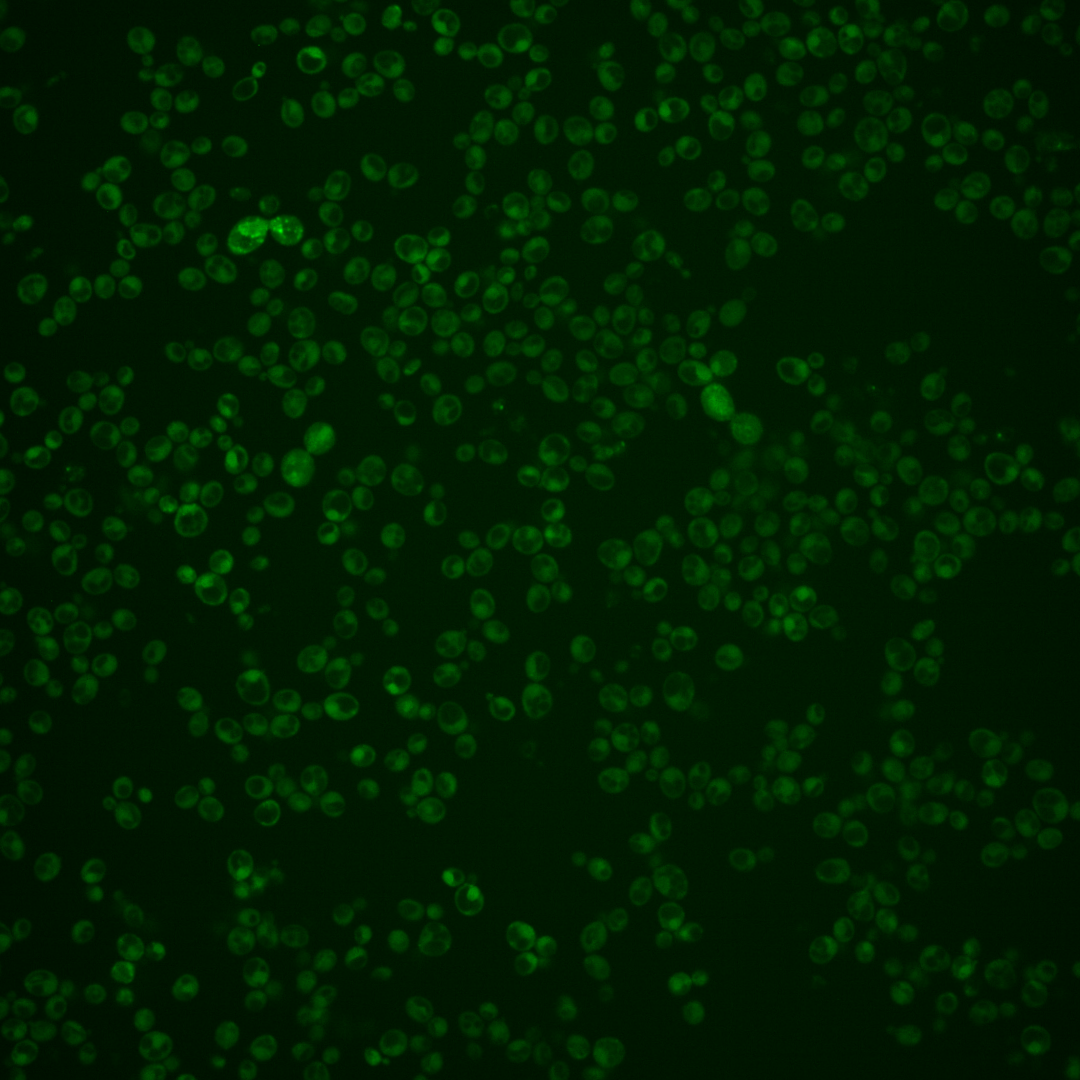
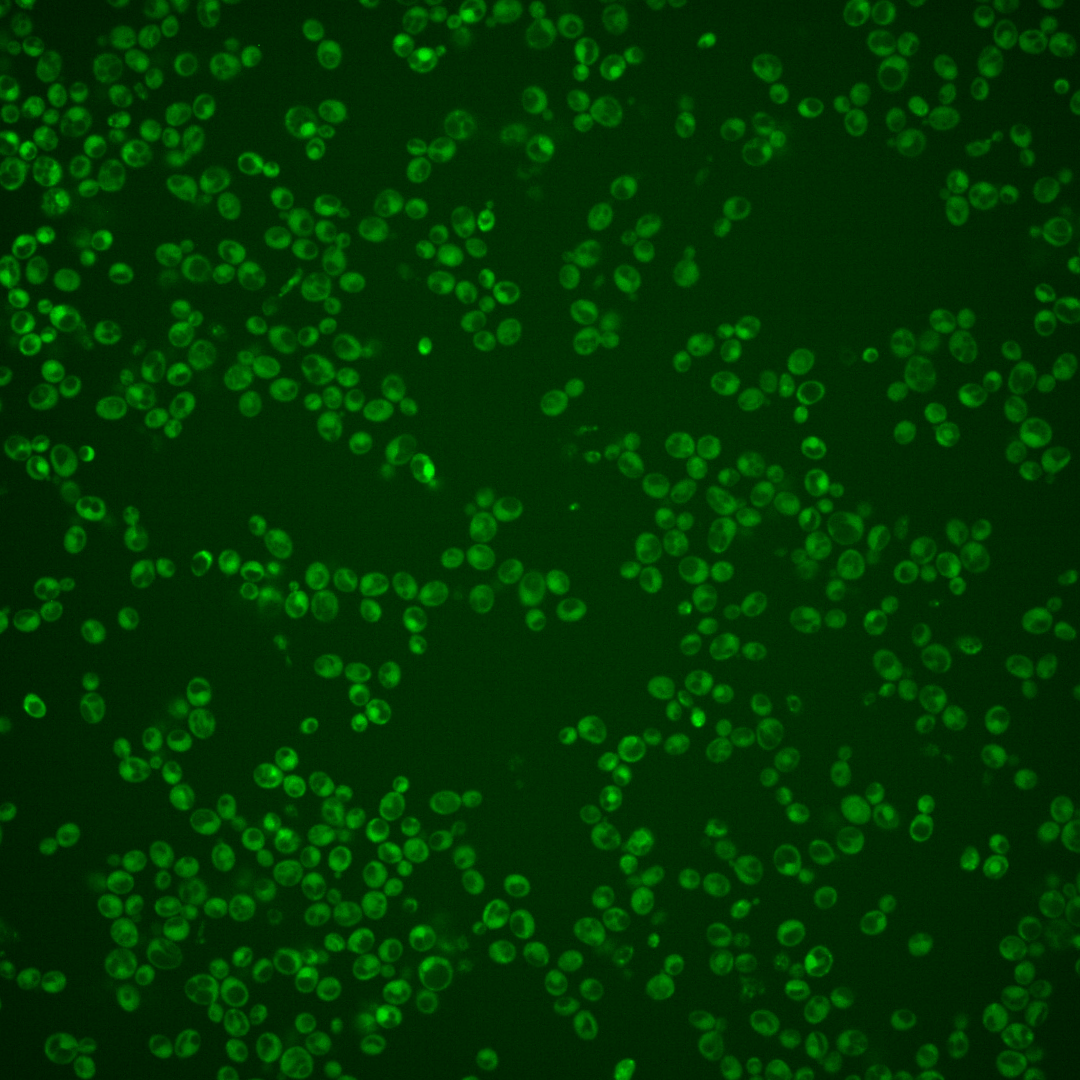
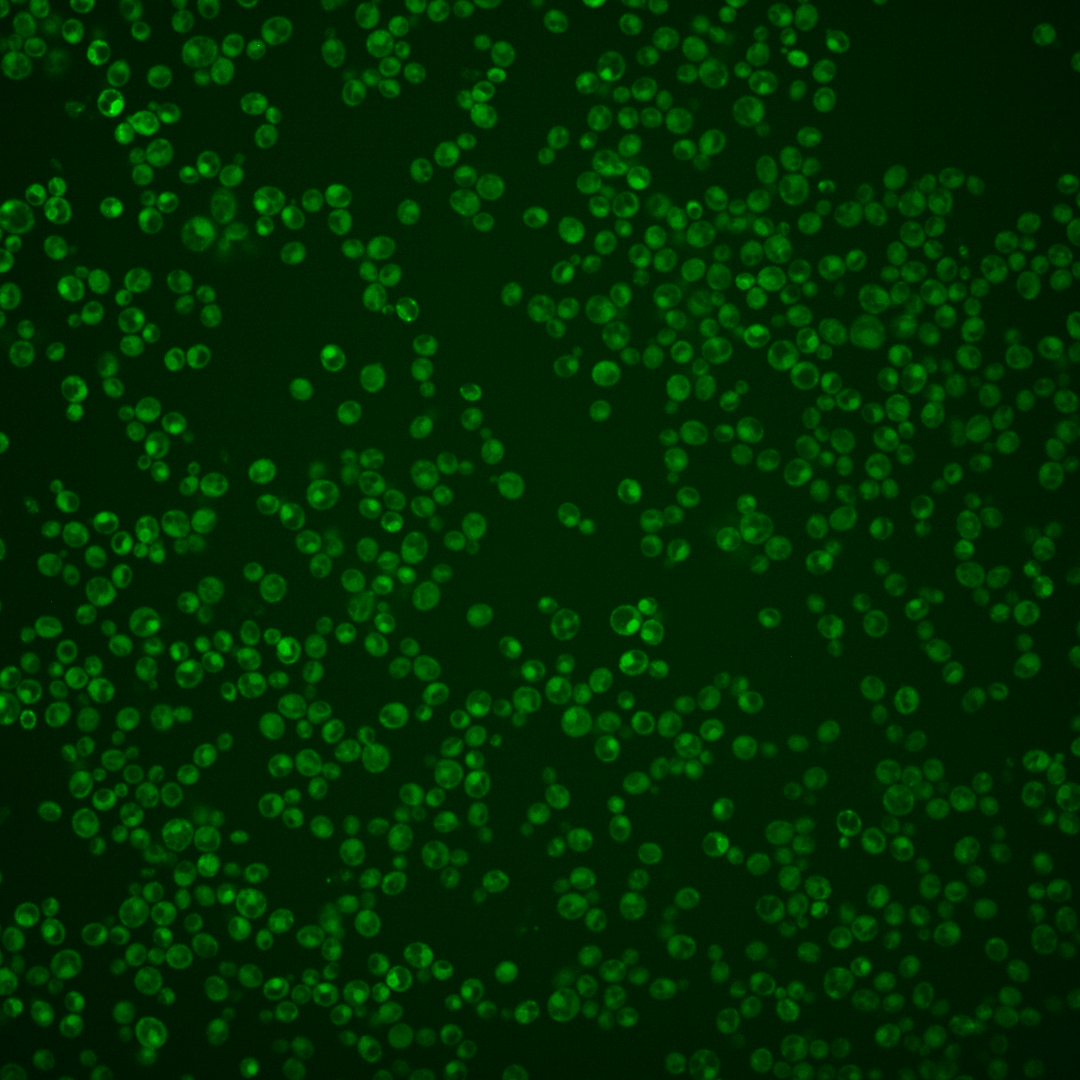

| Standard name | |
|---|---|
| Human Ortholog | |
| Description | Alcohol acetyltransferase; may play a role in steroid detoxification; forms volatile esters during fermentation, which is important for brewing and winemaking |
Micrographs




















































































Sub-cellular Localization
Yeast GFP Assignment
Protein Abundance
Localization Change
External localization resources
| ensLOC | DeepLoc | |||||||||||||||||||||||
|---|---|---|---|---|---|---|---|---|---|---|---|---|---|---|---|---|---|---|---|---|---|---|---|---|
| Localization | WT1 | WT2 | WT3 | RAP60 | RAP140 | RAP220 | RAP300 | RAP380 | RAP460 | RAP540 | RAP620 | RAP700 | HU80 | HU120 | HU160 | rpd3Δ_1 | rpd3Δ_2 | rpd3Δ_3 | WT1 | WT2 | WT3 | AF100 | AF140 | AF180 |
| Cortical Patches | 0 | 1 | 0 | 0 | 0 | 0 | 0 | 0 | 0 | 0 | 1 | 0 | 0 | 0 | 0 | 6 | 1 | 0 | 1 | 5 | 5 | 0 | 4 | 5 |
| Bud | 1 | 0 | 1 | 5 | 1 | 5 | 8 | 10 | 6 | 17 | 3 | 6 | 1 | 1 | 0 | 2 | 0 | 0 | 4 | 3 | 5 | 1 | 5 | 8 |
| Bud Neck | 0 | 1 | 1 | 0 | 1 | 1 | 3 | 2 | 1 | 5 | 0 | 0 | 0 | 0 | 0 | 2 | 0 | 0 | 0 | 4 | 5 | 1 | 2 | 3 |
| Bud Site | 1 | 0 | 0 | 0 | 0 | 1 | 3 | 0 | 4 | 3 | 1 | 3 | 0 | 0 | 0 | 0 | 0 | 0 | – | – | – | – | – | – |
| Cell Periphery | 3 | 4 | 2 | 2 | 4 | 0 | 1 | 0 | 1 | 1 | 1 | 1 | 1 | 2 | 1 | 10 | 3 | 8 | 0 | 2 | 5 | 2 | 2 | 2 |
| Cytoplasm | 65 | 212 | 278 | 174 | 230 | 274 | 352 | 419 | 258 | 388 | 95 | 144 | 180 | 234 | 226 | 217 | 116 | 80 | 63 | 163 | 160 | 82 | 133 | 118 |
| Endoplasmic Reticulum | 0 | 19 | 2 | 0 | 2 | 1 | 0 | 4 | 0 | 1 | 0 | 1 | 2 | 2 | 3 | 14 | 8 | 5 | 31 | 35 | 29 | 11 | 6 | 8 |
| Endosome | 4 | 0 | 0 | 1 | 5 | 6 | 5 | 3 | 1 | 0 | 1 | 1 | 1 | 0 | 1 | 12 | 12 | 2 | 1 | 2 | 4 | 3 | 1 | 3 |
| Golgi | 0 | 0 | 0 | 0 | 0 | 0 | 0 | 0 | 0 | 0 | 0 | 0 | 0 | 0 | 0 | 3 | 2 | 0 | 0 | 0 | 0 | 0 | 0 | 0 |
| Mitochondria | 4 | 9 | 30 | 25 | 38 | 136 | 227 | 209 | 160 | 222 | 75 | 113 | 1 | 2 | 0 | 21 | 2 | 2 | 32 | 27 | 64 | 10 | 15 | 14 |
| Nucleus | 0 | 1 | 0 | 0 | 0 | 2 | 1 | 1 | 1 | 1 | 0 | 0 | 1 | 1 | 1 | 5 | 1 | 4 | 0 | 0 | 0 | 0 | 0 | 0 |
| Nuclear Periphery | 0 | 2 | 0 | 0 | 0 | 0 | 1 | 1 | 0 | 1 | 0 | 0 | 0 | 0 | 1 | 0 | 0 | 0 | 0 | 0 | 0 | 0 | 1 | 0 |
| Nucleolus | 1 | 0 | 0 | 2 | 0 | 1 | 2 | 0 | 1 | 0 | 0 | 1 | 1 | 0 | 0 | 1 | 0 | 0 | 0 | 0 | 0 | 0 | 0 | 1 |
| Peroxisomes | 1 | 0 | 0 | 1 | 1 | 0 | 0 | 0 | 1 | 0 | 0 | 0 | 0 | 0 | 0 | 0 | 0 | 0 | 0 | 0 | 0 | 0 | 0 | 0 |
| SpindlePole | 3 | 0 | 0 | 1 | 3 | 2 | 11 | 9 | 7 | 2 | 5 | 2 | 0 | 0 | 0 | 1 | 0 | 0 | 2 | 1 | 2 | 1 | 3 | 3 |
| Vac/Vac Membrane | 3 | 6 | 3 | 1 | 9 | 9 | 8 | 2 | 2 | 1 | 2 | 0 | 1 | 0 | 4 | 51 | 40 | 11 | 8 | 14 | 11 | 1 | 3 | 8 |
| Unique Cell Count | 79 | 241 | 299 | 191 | 266 | 356 | 508 | 553 | 342 | 509 | 154 | 212 | 185 | 238 | 235 | 296 | 169 | 106 | 152 | 263 | 303 | 119 | 185 | 183 |
| Labelled Cell Count | 86 | 255 | 317 | 212 | 294 | 438 | 622 | 660 | 443 | 642 | 184 | 272 | 189 | 242 | 237 | 345 | 185 | 112 | 152 | 263 | 303 | 119 | 185 | 183 |
Yeast GFP Assignment
Protein Abundance
| Screen | WT1 | WT2 | WT3 | RAP60 | RAP140 | RAP220 | RAP300 | RAP380 | RAP460 | RAP540 | RAP620 | RAP700 | HU80 | HU120 | HU160 | rpd3Δ_1 | rpd3Δ_2 | rpd3Δ_3 | AF100 | AF140 | AF180 |
|---|---|---|---|---|---|---|---|---|---|---|---|---|---|---|---|---|---|---|---|---|---|
| Mean Cell GFP Intensity (1e-4) | 4.0 | 4.4 | 3.8 | 3.9 | 3.8 | 3.3 | 2.7 | 3.2 | 3.0 | 2.6 | 3.0 | 2.5 | 4.9 | 4.5 | 4.8 | 6.6 | 7.6 | 8.0 | 4.4 | 4.5 | 5.7 |
| Std Deviation (1e-4) | 0.7 | 0.8 | 1.1 | 1.2 | 1.3 | 1.5 | 0.9 | 1.1 | 1.4 | 0.9 | 2.1 | 0.8 | 2.2 | 1.5 | 2.0 | 1.5 | 1.8 | 1.6 | 1.7 | 1.8 | 2.5 |
| Intensity Change (Log2) | – | – | – | 0.01 | -0.02 | -0.21 | -0.51 | -0.27 | -0.33 | -0.56 | -0.37 | -0.6 | 0.36 | 0.23 | 0.33 | 0.79 | 1.0 | 1.07 | 0.21 | 0.22 | 0.57 |
Localization Change
| Localization | RAP60 | RAP140 | RAP220 | RAP300 | RAP380 | RAP460 | RAP540 | RAP620 | RAP700 | HU80 | HU120 | HU160 | rpd3Δ_1 | rpd3Δ_2 | rpd3Δ_3 |
|---|---|---|---|---|---|---|---|---|---|---|---|---|---|---|---|
| Actin | – | – | – | – | – | – | – | – | – | – | – | – | – | – | – |
| Bud | – | – | – | – | – | – | – | – | – | – | – | – | 0 | 0 | – |
| Bud Neck | – | – | – | – | – | – | – | – | – | – | – | – | 0 | 0 | – |
| Bud Site | – | – | – | – | – | – | – | – | – | – | – | – | 0 | 0 | – |
| Cell Periphery | – | – | – | – | – | – | – | – | – | – | – | – | 0 | 0 | – |
| Cyto | – | – | – | – | – | – | – | – | – | – | – | – | – | – | – |
| Endoplasmic Reticulum | – | – | – | – | – | – | – | – | – | – | – | – | 0 | 0 | – |
| Endosome | – | – | – | – | – | – | – | – | – | – | – | – | 0 | 0 | – |
| Golgi | – | – | – | – | – | – | – | – | – | – | – | – | 0 | 0 | – |
| Mitochondria | – | – | – | – | – | – | – | – | – | – | – | – | 0 | 0 | – |
| Nuclear Periphery | – | – | – | – | – | – | – | – | – | – | – | – | 0 | 0 | – |
| Nuc | – | – | – | – | – | – | – | – | – | – | – | – | – | – | – |
| Nucleolus | – | – | – | – | – | – | – | – | – | – | – | – | 0 | 0 | – |
| Peroxisomes | – | – | – | – | – | – | – | – | – | – | – | – | 0 | 0 | – |
| SpindlePole | – | – | – | – | – | – | – | – | – | – | – | – | 0 | 0 | – |
| Vac | – | – | – | – | – | – | – | – | – | – | – | – | – | – | – |
| Cortical Patches | – | – | – | – | – | – | – | – | – | – | – | – | 0 | 0 | – |
| Cytoplasm | – | – | – | – | – | – | – | – | – | – | – | – | 0 | 0 | – |
| Nucleus | – | – | – | – | – | – | – | – | – | – | – | – | 0 | 0 | – |
| Vacuole | – | – | – | – | – | – | – | – | – | – | – | – | 6.9 | 8.2 | – |
External localization resources
Images






























Protein Concentration and Protein Localization Data
| R1 | R2 | R3 | ||||||||||||||||
|---|---|---|---|---|---|---|---|---|---|---|---|---|---|---|---|---|---|---|
| G1 Pre-START | G1 Post-START | S/G2 | Metaphase | Anaphase | Telophase | G1 Pre-START | G1 Post-START | S/G2 | Metaphase | Anaphase | Telophase | G1 Pre-START | G1 Post-START | S/G2 | Metaphase | Anaphase | Telophase | |
| Concentration | -0.0226 | -0.0968 | -0.0644 | -0.3793 | -0.745 | 0.1087 | 1.2009 | 0.6209 | 1.3377 | 1.0387 | 1.2596 | 1.0476 | 1.5045 | 1.8542 | 1.8692 | 1.6522 | 2.003 | 1.7318 |
| Actin | 0.031 | 0.0001 | 0.0165 | 0.0075 | 0.0003 | 0.0024 | 0.0133 | 0.0007 | 0.0054 | 0.0263 | 0.0137 | 0.008 | 0.0303 | 0.0012 | 0.0268 | 0.0003 | 0.0288 | 0.0013 |
| Bud | 0.0004 | 0.0001 | 0.0005 | 0.0002 | 0.0001 | 0.0003 | 0.0008 | 0.0007 | 0.0003 | 0.0008 | 0.0003 | 0.0003 | 0.0007 | 0.0015 | 0.0012 | 0.0002 | 0.0021 | 0.0002 |
| Bud Neck | 0.0015 | 0.0001 | 0.0079 | 0.0021 | 0.0001 | 0.0004 | 0.0148 | 0.0001 | 0.0002 | 0.0005 | 0.0009 | 0.0005 | 0.0015 | 0.0001 | 0.0011 | 0.0001 | 0.0062 | 0.0013 |
| Bud Periphery | 0.0006 | 0.0001 | 0.0009 | 0.0004 | 0.0002 | 0.0015 | 0.002 | 0.0018 | 0.0008 | 0.0009 | 0.0003 | 0.0012 | 0.001 | 0.0006 | 0.0047 | 0.0003 | 0.0081 | 0.0003 |
| Bud Site | 0.0014 | 0.0015 | 0.0116 | 0.0027 | 0 | 0.0002 | 0.0128 | 0.0034 | 0.0007 | 0.014 | 0.0025 | 0.0001 | 0.0095 | 0.0062 | 0.0079 | 0.004 | 0.0047 | 0.0003 |
| Cell Periphery | 0.0005 | 0.0009 | 0.0012 | 0.0002 | 0.0001 | 0.0002 | 0.0012 | 0.0004 | 0.0003 | 0.0002 | 0.0001 | 0.0001 | 0.0003 | 0.0003 | 0.0005 | 0.0001 | 0.0012 | 0.0001 |
| Cytoplasm | 0.1227 | 0.1541 | 0.1973 | 0.1434 | 0.0272 | 0.2571 | 0.029 | 0.079 | 0.0888 | 0.0354 | 0.0603 | 0.1442 | 0.0648 | 0.1094 | 0.1387 | 0.0903 | 0.098 | 0.1191 |
| Cytoplasmic Foci | 0.0191 | 0.0038 | 0.0122 | 0.031 | 0.023 | 0.0107 | 0.054 | 0.0152 | 0.0145 | 0.0457 | 0.0935 | 0.0119 | 0.0282 | 0.0038 | 0.0078 | 0.021 | 0.0089 | 0.0182 |
| Eisosomes | 0.0005 | 0.0002 | 0.0013 | 0.0007 | 0.0001 | 0.0001 | 0.0004 | 0.0005 | 0.0006 | 0.0004 | 0.0001 | 0.0002 | 0.0006 | 0.0002 | 0.0006 | 0.0001 | 0.0006 | 0.0001 |
| Endoplasmic Reticulum | 0.0067 | 0.0184 | 0.0076 | 0.0047 | 0.0006 | 0.0089 | 0.0027 | 0.017 | 0.0057 | 0.0007 | 0.0008 | 0.0223 | 0.0167 | 0.0305 | 0.0043 | 0.0018 | 0.0006 | 0.0028 |
| Endosome | 0.0114 | 0.0005 | 0.0174 | 0.0024 | 0.0053 | 0.005 | 0.0213 | 0.0067 | 0.022 | 0.0091 | 0.0321 | 0.0065 | 0.0122 | 0.0012 | 0.0067 | 0.0133 | 0.0029 | 0.0022 |
| Golgi | 0.0043 | 0.0001 | 0.0057 | 0.0005 | 0.0006 | 0.0006 | 0.0116 | 0.0009 | 0.001 | 0.0047 | 0.0387 | 0.0008 | 0.0054 | 0.0001 | 0.003 | 0.0013 | 0.0017 | 0.0004 |
| Lipid Particles | 0.0211 | 0.0008 | 0.0093 | 0.0017 | 0.0161 | 0.0011 | 0.045 | 0.0032 | 0.0032 | 0.0065 | 0.0758 | 0.0022 | 0.0069 | 0.0004 | 0.0019 | 0.0031 | 0.0039 | 0.0016 |
| Mitochondria | 0.002 | 0.0002 | 0.0097 | 0.0009 | 0.0043 | 0.0063 | 0.0046 | 0.0004 | 0.0014 | 0.005 | 0.0106 | 0.0024 | 0.0018 | 0.0002 | 0.0019 | 0.0007 | 0.0218 | 0.0009 |
| None | 0.7404 | 0.8163 | 0.6844 | 0.7858 | 0.9108 | 0.6894 | 0.6644 | 0.8634 | 0.834 | 0.8361 | 0.6012 | 0.7892 | 0.8 | 0.8379 | 0.7838 | 0.8563 | 0.7748 | 0.8376 |
| Nuclear Periphery | 0.0108 | 0.0004 | 0.0013 | 0.0008 | 0.0013 | 0.0058 | 0.0197 | 0.0011 | 0.0056 | 0.0007 | 0.0004 | 0.0016 | 0.0033 | 0.0012 | 0.0013 | 0.0005 | 0.0003 | 0.0023 |
| Nucleolus | 0.0005 | 0.0002 | 0.0016 | 0.0004 | 0.0004 | 0.0003 | 0.0014 | 0.0002 | 0.0007 | 0.0003 | 0.0007 | 0.0001 | 0.0006 | 0.0003 | 0.0003 | 0.0003 | 0.0047 | 0.0003 |
| Nucleus | 0.0034 | 0.0005 | 0.0018 | 0.0013 | 0.0004 | 0.0016 | 0.028 | 0.0007 | 0.003 | 0.0004 | 0.0004 | 0.0007 | 0.0016 | 0.0014 | 0.0007 | 0.0005 | 0.0029 | 0.0006 |
| Peroxisomes | 0.0121 | 0 | 0.0034 | 0.0028 | 0.0049 | 0.0003 | 0.0609 | 0.0024 | 0.0037 | 0.0103 | 0.0612 | 0.0057 | 0.008 | 0.0002 | 0.0047 | 0.0011 | 0.0233 | 0.0074 |
| Punctate Nuclear | 0.0047 | 0.0006 | 0.0018 | 0.0094 | 0.0025 | 0.0044 | 0.0063 | 0.0009 | 0.004 | 0.0011 | 0.004 | 0.0007 | 0.0045 | 0.002 | 0.0007 | 0.0014 | 0.0008 | 0.0021 |
| Vacuole | 0.0031 | 0.0011 | 0.0058 | 0.0012 | 0.0011 | 0.0023 | 0.0037 | 0.0012 | 0.003 | 0.0006 | 0.0019 | 0.0011 | 0.0016 | 0.0012 | 0.0011 | 0.0029 | 0.0034 | 0.0006 |
| Vacuole Periphery | 0.002 | 0 | 0.0008 | 0.0001 | 0.0006 | 0.001 | 0.002 | 0.0002 | 0.001 | 0.0003 | 0.0005 | 0.0003 | 0.0006 | 0.0001 | 0.0003 | 0.0004 | 0.0004 | 0.0002 |
Sequencing Data
| R1 | R2 | |||||||||
|---|---|---|---|---|---|---|---|---|---|---|
| G1 Post-START | S/G2 | Metaphase | Anaphase | Telophase | G1 Post-START | S/G2 | Metaphase | Anaphase | Telophase | |
| Gene Expression | 7.5482 | 15.9489 | 26.4006 | 21.6079 | 11.5659 | 7.544 | 19.6922 | 22.1864 | 15.6236 | 10.835 |
| Translational Efficiency | 0.8583 | 1.3245 | 1.0542 | 1.123 | 0.7314 | 0.7032 | 0.7399 | 0.7821 | 0.9061 | 0.5989 |
Hit Data
| Dataset | Hit |
|---|---|
| Protein Concentration | ✘ |
| Protein Localization | ✘ |
| Gene Expression | ✔ |
| Translational Efficiency | ✘ |
Endocytosis
| Temp | Actin Patch (Sac6-tdTomato) | Cortical Patch (Sla1-GFP) | Late Endosome (Snf7-GFP) | Vacuole (Vph1-GFP) |
|---|---|---|---|---|
| 37℃ | ||||
| RT |
Cell Cycle Omics
CYCLoPs (Atf2-GFP)
| Gene / Allele | Actin Patch (Sac6-tdTomato) | Cortical Patch (Sla1-GFP) | Late Endosome (Snf7-GFP) | Vacuole (Sac6-tdTomato) |
|---|
| Gene | Images |
|---|
| Gene | Images |
|---|
Images are not yet available
Images are not yet available